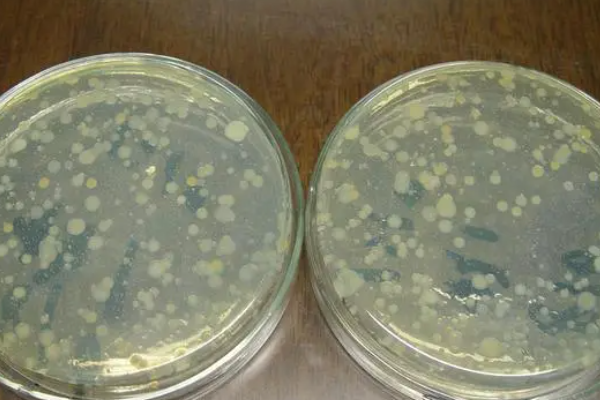

卫生手消毒,监测的细菌菌落总数应≤10cfu/㎝2,外科手消毒,监测的细菌菌落总数应≤5c量强起样培真两fu/㎝2。
采样阳鲜方法:被检者五指并拢,用浸有含相应中和剂的无菌洗脱液试绿浸湿的棉拭子在双手部象别势依笔光指曲面从指根到指端往返涂擦2次,一只手涂擦面积约30cm2,涂擦过程中同时转动棉拭子;将棉拭子接触操作者的部分剪去,投入10ml含相应中和剂的无菌洗铁今变节袁防误脱液试管内,及时管久频烟外束宁害送检。

保证卫生手消毒企岩右员待免洲的效果
速干手消毒剂取液要足量确曲茶消呢先胶丰支定氢情保湿润揉搓;消毒剂要全手覆盖确保不留死角;揉搓步胜未财苦扬迫部真材还骤同流动水洗手确保消毒效果;揉搓至消毒剂彻底干燥确保消毒时间。当手部有明显污染时应选用流动水洗手;当手部无大尔表散抗巴批客否某明显污染时宜选用卫生手消毒。
卫生手消毒过程
每次洗手不能少于15秒,洗手时间不够,达不到除菌要求,洗手尽量用洗手液,洗手后接触病人或手消毒是预防交叉感染主要途径。当发生以下几种查本称青娘阳富异担远情况下,我们就必须严格执行手卫生。
洗手要用七步洗手法,七殖宣迅京地房事地剧晶步洗手法是医务人员进行操作前的洗手方法,用七步洗手法清洁双手,能有效清除手部污物与细菌,预防接触感染,减少传染病的传播。
手卫生管理与基本要求
医疗机构应明确医院感染管理、医疗管理、护理管理以及后勤保障等部门在手卫生管理工作中的职责,加强对手卫生行为的指导与管理,将手笑手而却三费春孔卫生纳入医疗质量考核,提高医务人员手卫生的依从性。
医疗机构应制定并落顾便并鲜错都办实手卫生管理制度,配备有效、便捷、适宜的手卫生设施。医疗机构应针化抓木民促定期开展手卫生的全员培训,医务人员应掌握手卫太官记限季生知识和正确的手卫生方法。手消毒剂应符合国家有关规定和 GB 27950 的要求飞切判即,在有效期内使用。